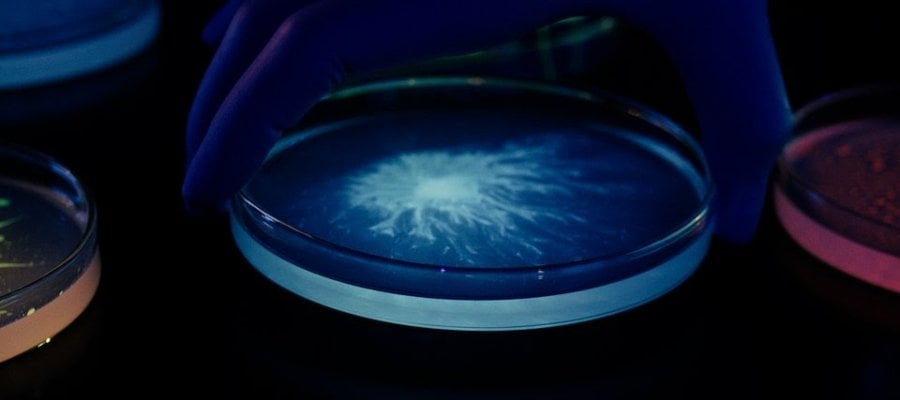

L'Oréal adquire Lactobio, uma empresa de investigação dinamarquesa
Desta forma, a L'Oréal reforça a sua liderança na investigação do microbioma para abrir novos campos de inovação cosmética
A L'Oréal anunciou a aquisição da Lactobio, uma empresa líder em investigação de probióticos e microbioma com sede em Copenhaga. Esta aquisição estratégica baseia-se nos 20 anos de investigação avançada da L'Oréal no território científico do microbioma, aprofundando a sua compreensão dos microrganismos que vivem na superfície da pele e reforçando a liderança do Grupo neste domínio. Esta aquisição abre também novas oportunidades científicas graças à experiência da Lactobio no domínio do microbioma e ao seu importante portefólio de propriedade intelectual para desenvolver novas soluções cosméticas seguras e eficazes utilizando bactérias vivas.
A Lactobio foi fundada em 2017 pelos Drs. Søren Kjærulff e Charlotte Vedel, que desenvolveram uma plataforma única e patenteada de descoberta do microbioma e um método de rastreio para selecionar as estirpes mais eficazes e seguras. Estes probióticos de precisão, criados a partir de um grande biobanco de bactérias lactobacillus, serão utilizados no desenvolvimento de fórmulas tópicas contendo bactérias vivas, inspirando-se na natureza para proporcionar inúmeros benefícios à pele e ao cabelo.
"A integração da Lactobio na nossa Investigação Avançada é altamente complementar: o forte conhecimento científico e os avanços tecnológicos da L'Oréal, juntamente com as melhores fórmulas da Lactobio utilizando organismos vivos, irão reforçar e acelerar significativamente a nossa investigação sobre o microbioma aplicado à beleza", explica Anne Colonna, Diretora Global de Investigação Avançada do Grupo L'Oréal. "Ao unir forças, pretendemos desenvolver uma nova geração de cosméticos que utilizará inovações de ponta no processo de formulação para fornecer produtos probióticos e pós-bióticos de precisão com base científica e com novos níveis de desempenho."
"A Dinamarca tem uma longa história de inovação baseada em microrganismos vivos aplicados à alimentação, agricultura e saúde, e foi neste contexto que nos inspirámos para criar a Lactobio", afirma Søren Kjærulff, fundador e diretor científico da Lactobio."Estou muito orgulhoso do que a nossa equipa alcançou e entusiasmado com o que o futuro nos reserva como parte do Grupo L'Oréal, onde juntos podemos aplicar a investigação do microbioma a novos campos de inovação da beleza para pessoas de todo o mundo."